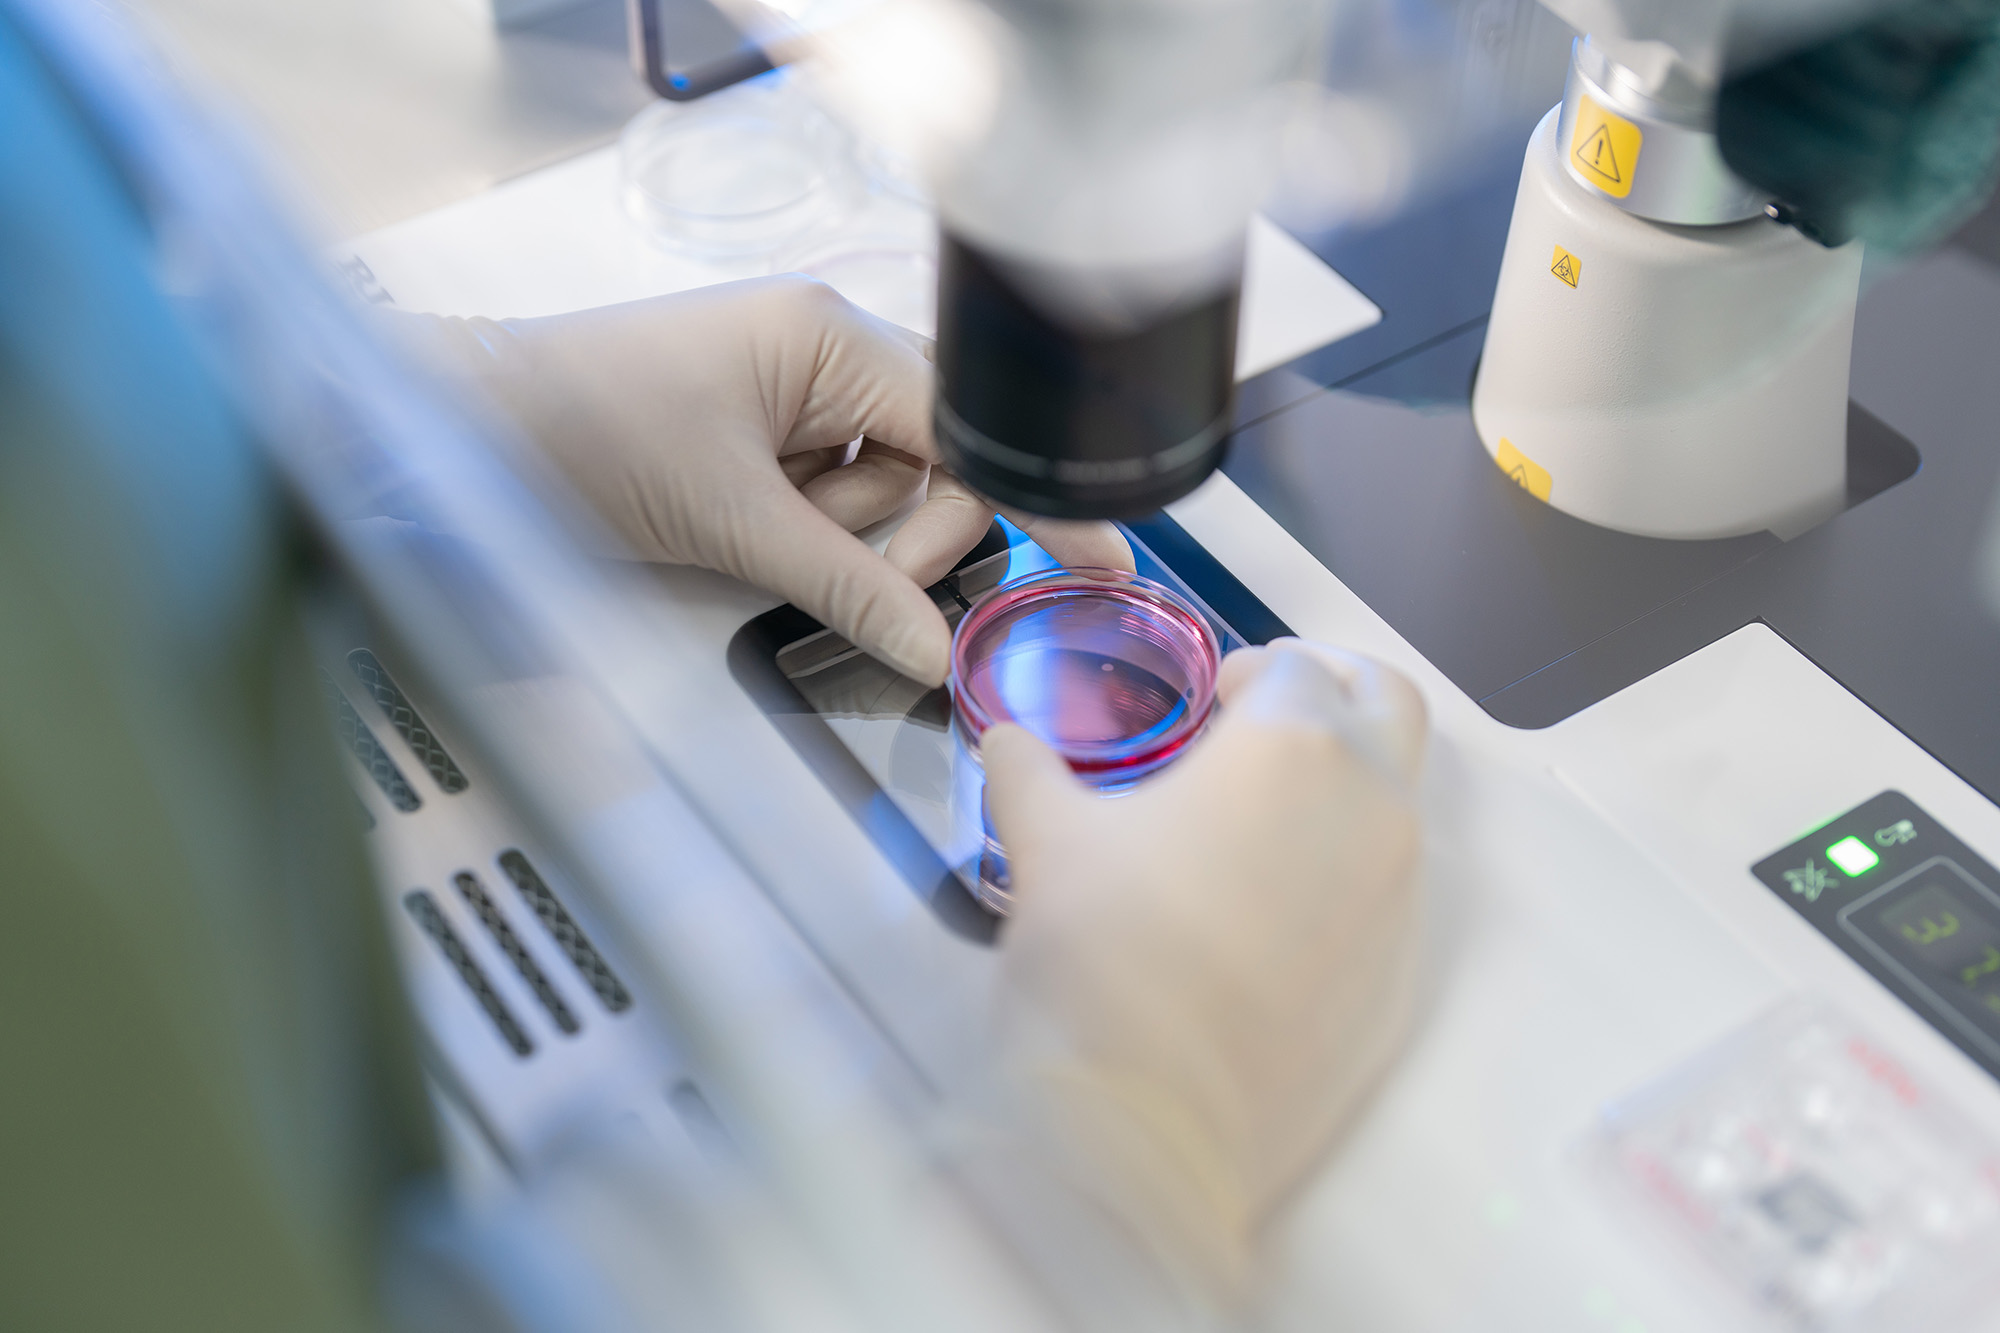

Gift Fertility (กิฟท์ เฟอร์ทิลิตี้) ผู้นำด้านเวชศาสตร์การเจริญพันธุ์ของไทย ประกาศลงนามบันทึกความเข้าใจ (MOU) ร่วมกับ บริษัท พริ้นซิเพิล แคปิตอล จำกัด (มหาชน) หรือ PRINC Group เพื่อร่วมกันจัดตั้งความร่วมมือเชิงกลยุทธ์ระยะยาว มุ่งพัฒนาโครงสร้างบริการด้านการรักษาผู้มีบุตรยากแบบบูรณาการ เป็นระบบ และขยายผลได้อย่างยั่งยืน
ความร่วมมือครั้งนี้ไม่ได้เป็นเพียงการขยายบริการทางการแพทย์ แต่เป็นก้าวสำคัญในการขับเคลื่อนวิสัยทัศน์ “Advancing Total Fertility Solution” ให้เกิดขึ้นอย่างเป็นรูปธรรม ภายใต้กรอบความร่วมมือเชิงกลยุทธ์ดังกล่าว จึงมีแผนพัฒนา Integrated Fertility Network ในฐานะโมเดลการดำเนินงานที่จะเชื่อมโยงศูนย์เฉพาะทางด้านเวชศาสตร์การเจริญพันธุ์เข้ากับเครือข่ายโรงพยาบาลของ PRINC Group อย่างเป็นระบบโมเดลดังกล่าวจะนำไปสู่การจัดตั้งบริษัทร่วมทุนเพื่อพัฒนาและบริหารศูนย์รักษาผู้มีบุตรยากโดยเฉพาะ พร้อมขยายจุดบริการผ่าน Satellite Clinics ภายในโรงพยาบาลเครือข่าย เพื่อเพิ่มการเข้าถึงบริการและสร้างความต่อเนื่องในการดูแลรักษา
มร.ไลโอเนล โซห์ วี ฉัว ประธานกรรมการ บริษัท กิฟท์ เฟอร์ทิลิตี้ จำกัด กล่าวว่า “ความร่วมมือในครั้งนี้สะท้อนมุมมองระยะยาวของเรา ต่ออนาคตของเวชศาสตร์การเจริญพันธุ์ในประเทศไทย ก้าวต่อไปของอุตสาหกรรมนี้ไม่ใช่การแข่งขันด้านเทคโนโลยีเพียงอย่างเดียว แต่คือการสร้างระบบบริการที่มีมาตรฐาน เชื่อมโยงกันได้ และสามารถขยายผลได้อย่างยั่งยืน เราเชื่อว่าการดูแลผู้มีบุตรยากไม่ควรถูกจำกัดด้วยโครงสร้างที่แยกส่วน แต่ควรถูกออกแบบเป็นเครือข่ายที่บริหารจัดการอย่างมืออาชีพ มีธรรมาภิบาลที่ชัดเจน และให้ความสำคัญกับผลลัพธ์ของผู้ป่วย การผสานความเชี่ยวชาญเฉพาะทางของ Gift Fertility เข้ากับศักยภาพเครือข่ายโรงพยาบาลของ PRINC Group จะช่วยสร้างโครงสร้างพื้นฐานใหม่ให้กับระบบการรักษา ซึ่งไม่เพียงยกระดับผลลัพธ์ทางคลินิก แต่ยังสร้างคุณค่าในระยะยาวให้กับระบบสุขภาพโดยรวม”

จากเทคโนโลยี สู่ระบบที่สร้างความเชื่อมั่นในระยะยาว
Gift Fertility เชื่อว่าความสำเร็จของการรักษาผู้มีบุตรยากไม่ได้เกิดจากเครื่องมือที่ทันสมัยเพียงอย่างเดียว แต่เกิดจากระบบการทำงานที่ออกแบบอย่างรอบคอบและมีมาตรฐานชัดเจน แนวคิดนี้สะท้อนผ่านองค์ประกอบสำคัญ 4 ด้าน ได้แก่ การเลือกใช้เทคโนโลยีที่มีหลักฐานรองรับ ทีมแพทย์และผู้เชี่ยวชาญที่มีประสบการณ์ มาตรฐานการดูแลที่สม่ำเสมอ และระบบกำกับติดตามผลลัพธ์อย่างต่อเนื่อง แม้จะมีการนำเทคโนโลยีที่ล้ำสมัยมาใช้เพื่อเพิ่มความแม่นยำในการรักษา แต่สิ่งที่ Gift Fertility ให้ความสำคัญไม่แพ้กัน คือการรักษามาตรฐานของกระบวนการดูแลในทุกขั้นตอน เพื่อให้ผู้ป่วยได้รับการรักษาที่ปลอดภัย มีความต่อเนื่อง และตรวจสอบได้
มร.ไลโอเนล โซห์ วี ฉัว กล่าวต่อว่า “เทคโนโลยีเป็นเพียงเครื่องมือ ความเชื่อมั่นที่แท้จริงเกิดจากระบบที่มีมาตรฐานและความรับผิดชอบในระดับองค์กร มีการติดตามและประเมินผลลัพธ์การรักษาอย่างสม่ำเสมอ เพื่อพัฒนาคุณภาพบริการให้ดีขึ้นอย่างต่อเนื่อง และรักษาความไว้วางใจของผู้รับบริการในระยะยาว”
Total Fertility Solution: มากกว่าการรักษา คือการออกแบบระบบการดูแล
ความร่วมมือกับ PRINC Group สอดคล้องกับวิสัยทัศน์ “Total Fertility Solution” ของ Gift Fertility ซึ่งครอบคลุมมิติการป้องกัน การรักษา และการส่งเสริมสุขภาวะ โมเดลใหม่นี้จะช่วยให้การประเมินเบื้องต้น การรักษา และการส่งต่อเชื่อมโยงกับการวินิจฉัยขั้นสูงและการดูแลแบบสหสาขาอย่างไร้รอยต่อ เพิ่มประสิทธิภาพการส่งต่อผู้ป่วย และยกระดับมาตรฐานบริการโดยรวม
วางรากฐานสู่เครือข่ายการรักษาผู้มีบุตรยากระดับภูมิภาค
ความร่วมมือครั้งนี้สะท้อนทิศทางใหม่ของอุตสาหกรรมสุขภาพไทย ที่มุ่งพัฒนา Specialty Network ภายใต้การบริหารจัดการแบบมืออาชีพ เพื่อรองรับทั้งผู้รับบริการชาวไทยและต่างชาติ ด้วยการผสานความเชี่ยวชาญด้านเวชศาสตร์การเจริญพันธุ์ของ Gift Fertility เข้ากับศักยภาพเครือข่ายโรงพยาบาลของ PRINC Group ความร่วมมือนี้จึงเป็นก้าวสำคัญในการสร้างมูลค่าระยะยาวให้แก่ผู้ป่วย บุคลากรทางการแพทย์ และระบบสุขภาพไทยโดยรวม
ด้าน นพ.วิชญเวทย์ รักษ์กุลชน และ นายฆนัท ศิริสุวัฒน์ ประธานบริหารร่วม (Co-CEO) บริษัท พริ้นซิเพิล แคปิตอล จำกัด (มหาชน) เปิดเผยว่า “การร่วมมือกับ Gift Fertility ในครั้งนี้ถือเป็นก้าวสำคัญของ PRINC Group ในการยกระดับศักยภาพของโรงพยาบาลในเครือ เพื่อตอบรับกับความต้องการของสังคมที่มีปัญหาเรื่องการมีบุตรยากเพิ่มสูงขึ้น เราเชื่อมั่นว่าด้วยเครือข่ายโรงพยาบาลที่ครอบคลุมของเรา ผสานกับความเชี่ยวชาญระดับโลกของ Gift Fertility จะทำให้ผู้รับบริการสามารถเข้าถึงเทคโนโลยีที่มีมาตรฐานในราคาที่เข้าถึงง่าย”


